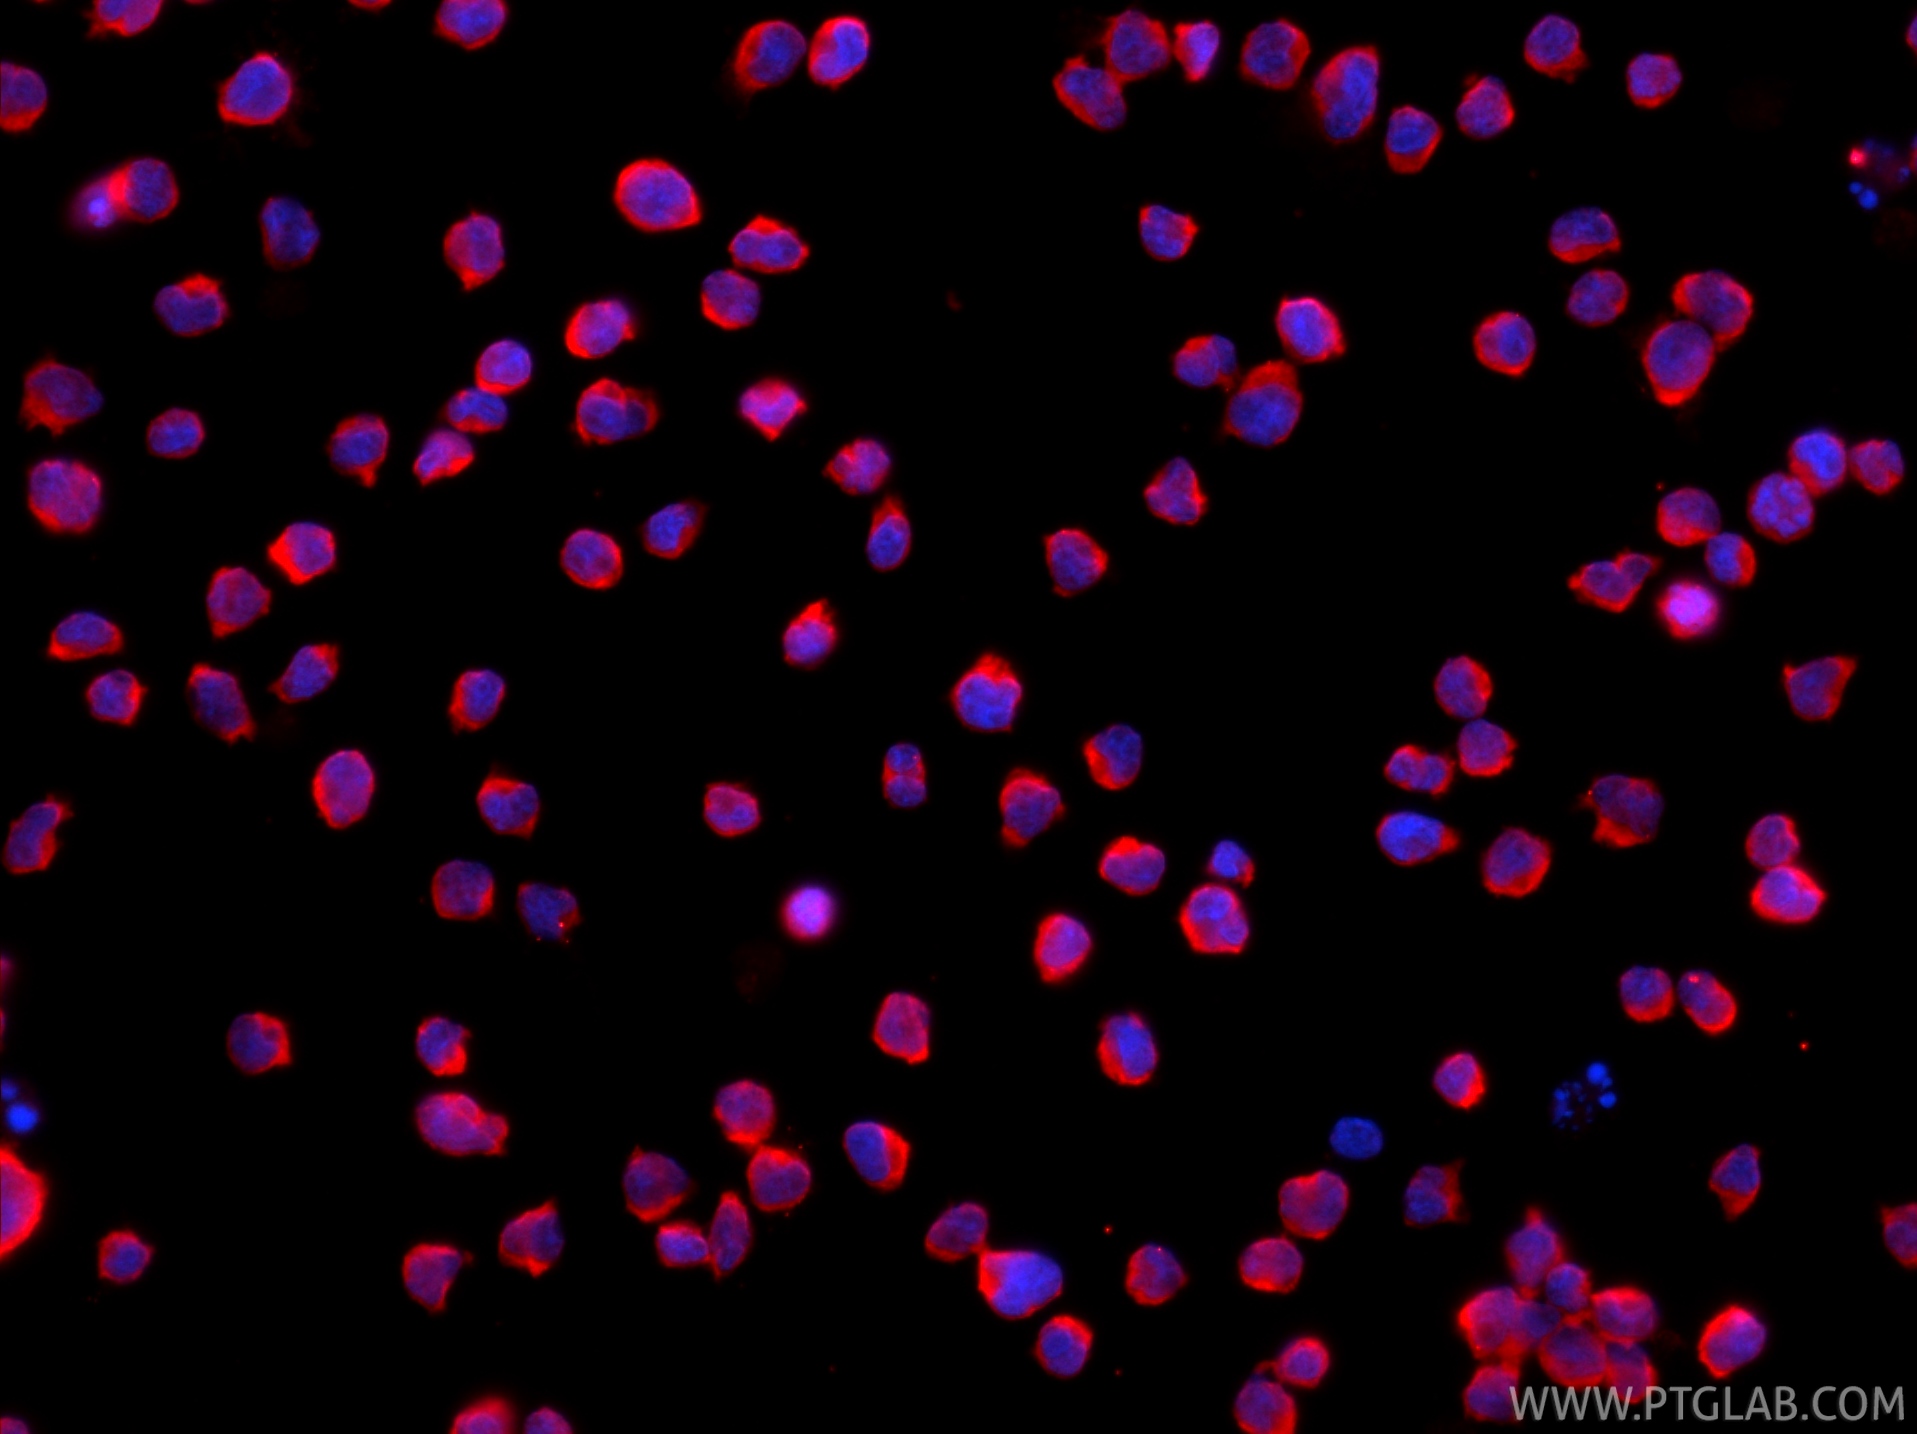
IF Staining of Jurkat using CL594-86933-2

验证数据展示
经过测试的应用
| Positive IF/ICC detected in | Jurkat cells |
| Positive FC (Intra) detected in | Jurkat cells |
推荐稀释比
| 应用 | 推荐稀释比 |
|---|---|
| Immunofluorescence (IF)/ICC | IF/ICC : 1:50-1:500 |
| Flow Cytometry (FC) (INTRA) | FC (INTRA) : 0.4 ug per 10^6 cells in a 100 µl suspension |
| It is recommended that this reagent should be titrated in each testing system to obtain optimal results. | |
| Sample-dependent, Check data in validation data gallery. | |
产品信息
CL594-86933-2 targets VAV1 in IF/ICC, FC (Intra) applications and shows reactivity with human samples.
| 经测试应用 | IF/ICC, FC (Intra) Application Description |
| 经测试反应性 | human |
| 免疫原 |
CatNo: Ag38665 Product name: Recombinant human VAV1 protein Source: e coli.-derived, PET30a Tag: 6*His Domain: 442-790 aa of BC013361 Sequence: EQFEMAISNIYPENATANGHDFQMFSFEETTSCKACQMLLRGTFYQGYRCHRCRASAHKECLGRVPPCGRHGQDFPGTMKKDKLHRRAQDKKRNELGLPKMEVFQEYYGLPPPPGAIGPFLRLNPGDIVELTKAEAEQNWWEGRNTSTNEIGWFPCNRVKPYVHGPPQDLSVHLWYAGPMERAGAESILANRSDGTFLVRQRVKDAAEFAISIKYNVEVKHIKIMTAEGLYRITEKKAFRGLTELVEFYQQNSLKDCFKSLDTTLQFPFKEPEKRTISRPAVGSTKYFGTAKARYDFCARDRSELSLKEGDIIKILNKKGQQGWWRGEIYGRVGWFPANYVEEDYSEYC 种属同源性预测 |
| 宿主/亚型 | Rabbit / IgG |
| 抗体类别 | Recombinant |
| 产品类型 | Antibody |
| 全称 | vav 1 guanine nucleotide exchange factor |
| 别名 | Proto oncogene vav, Proto-oncogene vav, VAV |
| 计算分子量 | 845 aa, 98 kDa |
| 观测分子量 | 98 kDa |
| GenBank蛋白编号 | BC013361 |
| 基因名称 | VAV1 |
| Gene ID (NCBI) | 7409 |
| RRID | AB_3748263 |
| 偶联类型 | CoraLite®594 Fluorescent Dye |
| 最大激发/发射波长 | 588 nm / 604 nm |
| 激发激光 | Yellow-Green Laser (561 nm) |
| 形式 | Liquid |
| 纯化方式 | Protein A purification |
| UNIPROT ID | P15498 |
| 储存缓冲液 | PBS with 50% glycerol, 0.05% Proclin300, 0.5% BSA, pH 7.3. |
| 储存条件 | Store at -20°C. Avoid exposure to light. Stable for one year after shipment. Aliquoting is unnecessary for -20oC storage. |
背景介绍
Vav proteins mainly act as enzymes that catalyze the activation step of Rho subfamily GTPases during cell signaling. There are three family members:VAV1, VAV2 and VAV3. Vav1 is specifically expressed in the hematopoietic system, whereas Vav2 and Vav3 are more ubiquitously expressed (PMID:14607270). Vav1 is physiologically active as a GDP/GTP nucleotide exchange factor (GEF) in the hematopoietic system (PMID:31654719).
实验方案
| Product Specific Protocols | |
|---|---|
| FC protocol for CL594 VAV1 antibody CL594-86933-2 | Download protocol |
| IF protocol for CL594 VAV1 antibody CL594-86933-2 | Download protocol |
| Standard Protocols | |
|---|---|
| Click here to view our Standard Protocols |